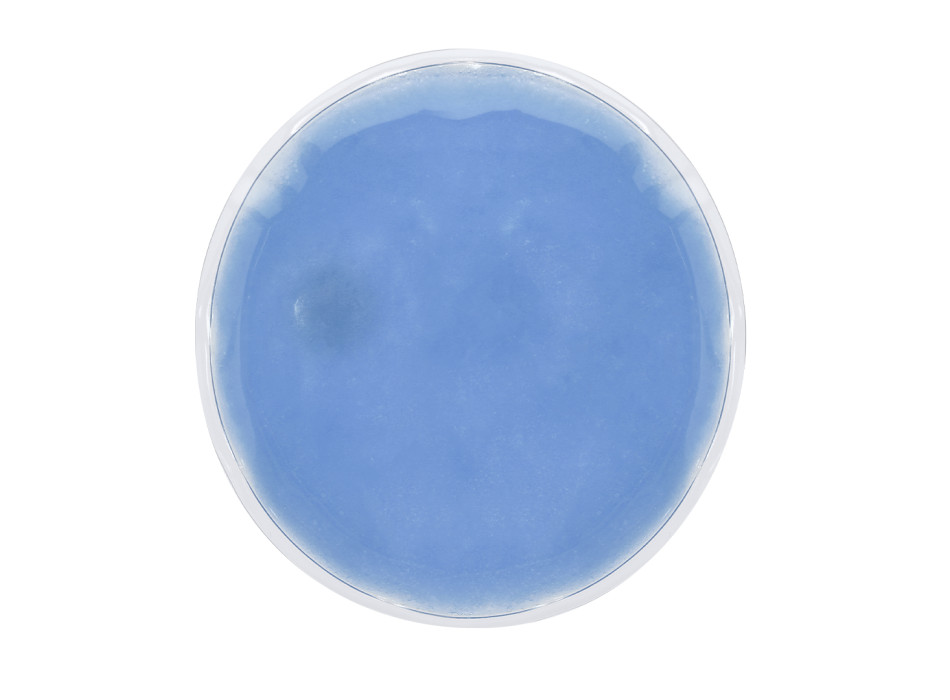
Kison

SPEDIZIONE SEMPRE GRATIS
Servizio clienti 02 86882878
-
ABBIGLIAMENTO
- AGENDE E CALENDARI
-
SHOPPER, ZAINI, BORSE
-
SCRITTURA
-
TEMPO LIBERO
-
EVENTI E UFFICIO
-
BORRACCE E TAZZE
-
TECNOLOGIA
-
ALTRI GADGET
-
Prodotti Ecologici Personalizzati
-
Articoli Personalizzati per la Cucina
-
Igiene e Prevenzione
-
Portachiavi Personalizzati
-
Attrezzi Personalizzati
-
Dolciumi Personalizzati
-
Orologi Personalizzati
-
Altri Articoli Pubblicitari Personalizzati
-
Gadget Personalizzati per Animali
-
Accessori per Auto Personalizzati
-